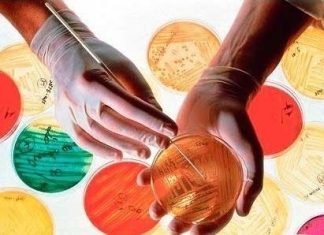
Микробиологический контроль: как лабораториям снизить совокупные риски

Совет Евразийской экономической комиссии (ЕЭК) упростил процедуры таможенного оформления для некоторых скоропортящихся товаров, в том числе для фармацевтической продукции. Об этом сообщает «ФВ» со ссылкой на соответствующее решение, опубликованное на правовом портале межнационального регулятора.
«Проведение таможенных операций в первоочередном порядке возможно для препаратов крови человека и животных, иммунологических и биотехнологических препаратов. Под ускоренные таможенные процедуры попали также препараты из органов и тканей человека, а также альбумины и нуклеиновые кислоты», – пишет издание.
Документ вступает в силу с 17 ноября. Импортерам до 31 декабря 2023 года будут доступны упрощенные процедуры.
Нуклеиновые кислоты ранее вошли в расширенный список товаров для первоочередного таможенного оформления.